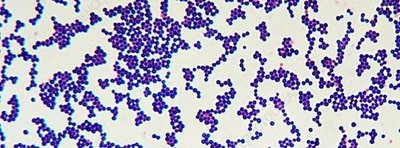
Gram-positive cocci under microscope
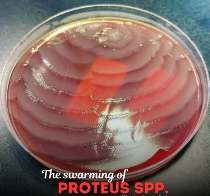
Swarming of Proteus spp. on agar plate

BackL 3.1: Bacterial Diversity, Structure, and Identification: A Comprehensive Study Guide
Study Guide - Smart Notes
Tailored notes based on your materials, expanded with key definitions, examples, and context.
L 3.1
Bacterial Diversity and Taxonomy
Evolution of Taxonomic Systems
The classification of living organisms has evolved from a simple two-kingdom system to a more complex six-kingdom and three-domain system, reflecting advances in molecular biology and genetics. Modern taxonomy relies heavily on genetic sequencing, particularly 16S rRNA gene sequencing and whole-genome sequencing, to distinguish between major groups of bacteria and archaea.
Two Kingdoms: Early systems classified life as either Plantae or Animalia.
Six Kingdoms/Three Domains: Modern systems recognize Bacteria, Archaea, and Eukarya as the three domains, with further subdivision into kingdoms such as Protista, Fungi, Plantae, and Animalia.
Technological Advances: Molecular techniques have revealed many uncultured bacterial species, expanding our understanding of microbial diversity.


Domains of Life: Bacteria and Archaea
Domain Archaea
Archaea are prokaryotic microorganisms distinct from bacteria, often inhabiting extreme environments but also found in more common habitats. They possess unique membrane lipids and genetic sequences.
Habitats: Extreme environments such as deep-sea vents, hot springs, alkaline or acidic waters, and anoxic muds.
Examples: Methanogens (produce methane in digestive tracts), Halobacterium (thrives in high salt concentrations).
Unique Features: Some archaea use light-sensitive pigments like bacteriorhodopsin for energy.


Domain Bacteria
Bacteria are highly diverse prokaryotes found in nearly every environment on Earth. They exhibit a variety of shapes, arrangements, and metabolic capabilities.
Shapes: Cocci (spherical), Bacilli (rod-shaped), Spirilla (spiral), Vibrios (comma-shaped), and others.
Colony Morphology: Bacterial colonies can be distinguished by their shape, margin, and surface characteristics.


Bacterial Cell Wall Structure and Gram Staining
Gram Stain Technique
The Gram stain is a differential staining technique that classifies bacteria based on cell wall structure. It is essential for bacterial identification in clinical and research settings.
Gram-Positive Bacteria: Thick peptidoglycan layer; stains purple.
Gram-Negative Bacteria: Thin peptidoglycan layer and outer membrane; stains pink.
Steps: Heat-fix, crystal violet, iodine (mordant), alcohol decolorization, safranin counterstain.


Acid-Fast Stain
The acid-fast stain differentiates bacteria with waxy mycolic acids in their cell walls, such as Mycobacterium species (e.g., tuberculosis and leprosy pathogens).
Mycolic Acids: Provide resistance to desiccation and chemical damage.
Clinical Importance: Used to identify Mycobacterium tuberculosis and M. leprae.

Major Bacterial Phyla
Phylum Firmicutes
Firmicutes are Gram-positive bacteria with low GC content. They include medically important genera and can form endospores for survival in harsh conditions.
Classes: Clostridia (anaerobes), Bacilli (aerobes/facultative anaerobes).
Examples: Bacillus, Clostridium, Staphylococcus, Streptococcus.
Endospores: Resistant structures for survival; do not stain with Gram stain.

Phylum Mycoplasma
Mycoplasmas lack a cell wall, making them resistant to antibiotics that target cell wall synthesis. They are among the smallest free-living organisms and include several human pathogens.
Examples: Mycoplasma pneumoniae (atypical pneumonia), M. genitalium (pelvic inflammatory disease).
Laboratory Challenge: Difficult to detect due to small size and lack of cell wall.
Phylum Cyanobacteria
Cyanobacteria, also known as blue-green algae, are photosynthetic bacteria capable of nitrogen fixation. They are important primary producers in aquatic ecosystems.
Photosynthesis: Occurs in thylakoid membranes, not chloroplasts.
Specialized Cells: Heterocysts (nitrogen fixation), Akinetes (spore-like survival cells).
Examples: Anabaena, Oscillatoria, Merismopedia, Nostoc, Gleocapsa.




Phylum Actinobacteria
Actinobacteria are Gram-positive bacteria with high GC content. They are notable for their role in soil ecology and antibiotic production.
Examples: Actinomyces, Streptomyces, Corynebacterium, Mycobacterium.
GC Content Calculation:
Clinical Importance: Includes pathogens and antibiotic producers.

Other Bacterial Phyla
Chlamydiae: Obligate intracellular pathogens (e.g., Chlamydia).
Spirochaetes: Spiral-shaped bacteria (e.g., Treponema, Borrelia).
Bacteroidetes: Includes Bacteroides, important in the human gut.
Proteobacteria: Largest group of Gram-negative bacteria, including Escherichia, Salmonella, Pseudomonas, Vibrio, and many others.

Bacterial Identification Techniques
Staining Methods
Direct Sample Staining: Used for rapid diagnosis (e.g., Gram stain of cerebrospinal fluid).
Cultured Organism Staining: Includes capsule stain (for visualizing capsules, a virulence factor) and Giemsa stain (for blood parasites and fungi).
Biochemical Testing
Bacteria are identified by their metabolic capabilities, such as lactose fermentation or citrate utilization. Clinical labs use panels of biochemical tests (e.g., Enterotube™) for rapid identification.
Metagenomics
Metagenomics involves sequencing genetic material directly from environmental samples, revealing the vast diversity of uncultured microbes. Less than 1% of microbes can be cultured in the lab.
Antibiotics and Bacterial Control
Definition and Mechanism
An antibiotic is a chemical produced by a microorganism that inhibits or kills other microorganisms. Many antibiotics are selective, targeting specific groups of bacteria or fungi. The zone of inhibition in a culture plate indicates the effectiveness of an antibiotic.
Therapeutic Index: Ratio of the toxic dose to the effective dose in humans.
Antifungal Agents: Antibiotics that target fungi are specifically called antifungal agents.
Laboratory Safety and Aseptic Technique
Best Practices
Proper aseptic technique is essential to prevent contamination of cultures and protect laboratory personnel. This includes wearing protective clothing, disinfecting work surfaces, washing hands, and proper disposal of contaminated materials.
Flaming Instruments: Sterilize nonflammable tools before and after use.
Disposal: Used swabs and toothpicks must be discarded in designated containers.